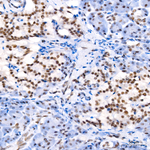
MLH1 Antibody in Immunohistochemistry (Paraffin) (IHC (P))

Search
Invitrogen
MLH1 Recombinant Rabbit Monoclonal Antibody (8K1T2)
{{$productOrderCtrl.translations['antibody.pdp.commerceCard.promotion.promotions']}}
{{$productOrderCtrl.translations['antibody.pdp.commerceCard.promotion.viewpromo']}}
{{$productOrderCtrl.translations['antibody.pdp.commerceCard.promotion.promocode']}}: {{promo.promoCode}} {{promo.promoTitle}} {{promo.promoDescription}}. {{$productOrderCtrl.translations['antibody.pdp.commerceCard.promotion.learnmore']}}
图: 1 / 6
MLH1 Antibody (MA569434) in IHC (P)

Please note: We are reviewing Western blot images included in the antibody testing data in our catalog, including those provided by third parties. Unless expressly labeled or annotated as “raw-unedited”, Western blot images included in the antibody testing data in our catalog may have been edited, optimized or otherwise adjusted for presentation.
产品信息
MA569434
种属反应
宿主/亚型
Expression System
分类
类型
克隆号
抗原
偶联物
形式
浓度
规格
纯化类型
保存液
内含物
保存条件
运输条件
靶标信息
MLH1 is a DNA mismatch repair protein. The repair of mismatch DNA is essential to maintaining the integrity of genetic information over time. An alteration of microsatellite repeats is the result of slippage owing to strand misalignment during DNA replication and is referred to as microsatellite instability (MSI). These defects in DNA repair pathways have been related to human carcinogenesis. The importance of mismatch repair genes became apparent with the identification of the genetic basis for hereditary nonpolyposis colon cancer (HNPC). MSHS2 is involved in the initial cognition of mismatch nucleotides during the replication mismatch repair process. It is thought that after MSH2 binds to a mismatched DNA duplex it is joined by a heterodimer of MLH1 and PMSH, which together help facilitate the later steps in mismatch repair.
仅用于科研。不用于诊断过程。未经明确授权不得转售。
篇参考文献 (0)
生物信息学
蛋白别名: colon cancer, nonpolyposis type 2; DNA mismatch repair protein Mlh1; MGC5172; MLH-1; MutL protein homolog 1
基因别名: 1110035C23Rik; AI317206; AI325952; AI561766; COCA2; MLH1
UniProt ID: (Mouse) Q9JK91
Entrez Gene ID: (Mouse) 17350



